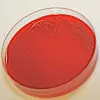

Paradoksal bakteriekamp
Finnene har funnet en måte å hindre bakterier i å bli motstandsdyktige mot antibiotika. Den går ut på å ødelegge antibiotikumet.
Denne artikkelen er over ti år gammel og kan inneholde utdatert informasjon.
Forskere fra firmaet Now Ipsat Therapies i Helsinki har laget en pille som rensker ut antibiotikarester som ikke tas opp fra tarmen. Det ser ut til å sette en stopper for både motstandsdyktige bakterier og mageproblemer, melder New Scientist.
Slik virker antibiotika…
Når man hiver innpå en pille med antibiotika, skjer omtrent dette: Tabletten løser seg opp og kroppen suger opp det meste av de virksomme stoffene mens de går gjennom den øvre delen av tarmen. Men noe av det antibiotiske stoffet fortsetter videre og ender opp i tykktarmen. Her blir det trøbbel.
Stoffet tar fort knekken på det meste av bakterielivet i tarmen, og mange av de naturlige fordøyelsesbakteriene må legge inn årene. Derfor er det ikke uvanlig at en skikkelig antibiotikakur ender i diaré eller annet festlig magetrøbbel. Og ikke nok med det.
?og antibiotikaresistens
Bakterier som av en eller annen grunn er resistente mot antibiotikat, får plutselig råde grunnen alene, og kan fort stable en skikkelig koloni på beina. Med feil type bakterier i farta blir man ordentlig syk.

Det dumme med en slik infeksjon er selvsagt at den ikke lar seg slå ned av antibiotikumet, og dermed må man til med en ny klasse bakteriedrepende stoffer. Med litt uflaks blir bakteriene motstandsdyktige mot dette også.
Tidligere forsøk har vist at de arbeidsledige antibiotikarestene kan henge igjen i tykktarmen i opptil to uker etter at man har tatt tablettene.
Nå ser det imidlertid ut til at en ny pille kan ordne opp i problemene.
Medisinbuster
Den omtalte tabletten inneholder et enzym som ødelegger beta-lactam-antibiotika, de virksomme stoffene i omtrent halvparten av alle de antibiotiske medisinene som finnes.
Trikset er at kapselen ikke åpner seg før den har kommet helt ned i den nedre delen av tarmen. Dermed kan tynntarmen fremdeles ta opp medisinen som vanlig, mens de problematiske restene blir uskadeliggjort før de får stelt i stand noe bråk.
Finnene har allerede testet ut enzymkapselen på seks frivillige, og sett at den ødelegger antibiotika i den nedre delen av tarmen uten å påvirke mengden av medisin som tas opp i blodet. Allerede neste år har Now Ipsat Therapies planer om nye tester som skal avgjøre om pillen kan hindre bakterieangrep i magen etter antibiotikakurer.
Og hvis pillen som skal rydde opp etter antibiotikapillen viser seg å ha bivirkninger? Vel, kan ikke noen bare finne opp enda en pille?
Lenke:
New Scientist: New weapon against superbugs destroys antibiotics